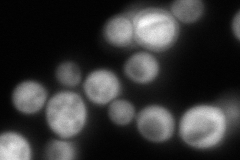

View description
Putative mitochondrial aconitase isozyme; similarity to Aco1p, an aconitase required for the TCA cycle; expression induced during growth on glucose, by amino acid starvation via Gcn4p, and repressed on ethanol
Localization:
Intensity:
Fold change:
Significance:
-
C’ GFP library in SD

mitochondria451.36 -
N' NOP1pr-GFP in SD

mitochondria97.3504 -
N' TEF2pr-mCherry in SD

mitochondria127.478 -
N' NATIVEpr-GFP in SD
cytosol333.902 -
N' TEF2pr-VC and Cyto-VN in SD

#N/A0 -
C’ GFP library in SD+DTT

mitochondria368.920.81No -
C’ GFP library in SD+H2O2

mitochondria414.750.91No -
C’ GFP library in Starvation Media

mitochondria102.580.22Yes -
C’ GFP library on the background of Pup2-DaMP

mitochondria -
C’ GFP library on the background of CCT mutant

mitochondria502.3041.11285No
